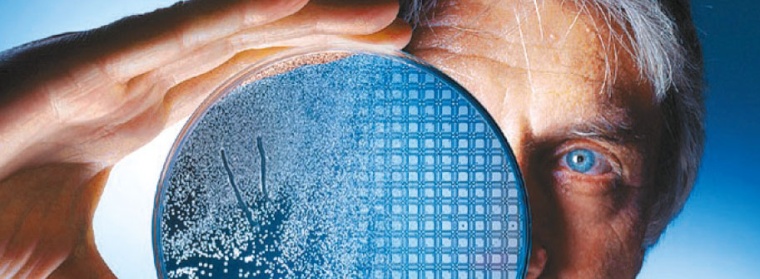
Abb. 1: Leberzellen

Virtuelle Leberzelle zur Medikamentenentwicklung

Virtuelle Leberzelle zur Medikamentenentwicklung – Forschungsprojekt zur Computersimulation von physiologischen Zellprozessen wie den Abbau von Arzneimitteln und Toxinen.
Das Verbundprojekt HepatoSys des BMBF ist in die zweite Projektphase eingetreten. Seit dem Jahr 2004 forschen deutschlandweit akademische Einrichtungen, aber auch Industriepartner, zur Systembiologie der Hepatozyte, der häufigsten Zellart in der Leber.
Mit dabei ist die Stuttgarter Insilico Biotechnology AG. Der biotechnologische Prozessentwickler aus der BioRegion Stern bringt seine große Erfahrung mit Modellierungstechniken in das Netzwerk ein und erhält dafür in den kommenden drei Jahren 250.000 € Fördermittel.
Ziel ist die Modellierung einer virtuellen Leberzelle, mit deren Hilfe physiologische Zellprozesse - wie beispielsweise der Abbau von Arzneimitteln und toxischen Substanzen – „in silico", also mittels Computer, nachvollzogen werden können.
Das Netzwerkprojekt unterstreicht die wachsende Bedeutung der Systembiologie für Forschung und Entwicklung in den Lebenswissenschaften und der Pharmaindustrie. Die „virtuelle Leberzelle" leistet einen fundamentalen Beitrag für die systembiologische Forschung in Deutschland.
Die Finanzmittel für die im Januar gestartete zweite Förderphase sind bereits bewilligt. Die Leber, für viele Aufgaben wie die Produktion lebenswichtiger Eiweißstoffe, die Aufrechterhaltung eines konstanten Glucose-Levels sowie die Produktion von Gallensalzen und Cholesterin verantwortlich, ist auch für den Abbau von Medikamenten und Giften zuständig.
Dass die Konzentration eines Medikaments im Blut zum einen von der verabreichten Dosis und zum anderen davon abhängt, wie schnell es durch Stoffwechselprozesse wieder abgebaut wird, ist allgemein bekannt.
Jedoch müssen, um therapeutisch optimale Dosierungen zu ermitteln, noch immer zeit- und kostenintensive Dosierungsfindungsstudien durchgeführt werden.
Weil die Erforschung von Risiken und Nebenwirkungen so enorm aufwändig ist, zieht sich die Zulassung einer Vielzahl neuer Medikamente über Jahre hin.
Virtuelle Repräsentationen ersetzen reale biologische Systeme
Diesen Aufwand will das HepatoSys-Kompetenznetzwerk mit seiner systembiologischen Forschung entscheidend reduzieren. Dabei steht die häufigste Zellart in der Leber, die Hepatozyte, im Fokus. Erstmals soll ein Modell zur Vorhersage der Detoxifikation pharmazeutisch wirksamer Substanzen in diesen Leberzellen erstellt werden.
Die entscheidende Voraussetzung für das Gelingen ist es, die Hepatozyte in der Gesamtheit ihrer komplexen und dynamischen Stoffwechselprozesse zu verstehen und als in silico-Leberzelldesign abzubilden.
Die virtuelle Repräsentation ist die Grundlage für Simulationen, die Experimente mit realen biologischen Systemen ersetzen und bei der Medikamentenentwicklung sowohl zur Zeit- und Kostenreduktion wie zur Verringerung der Zahl von Tierversuchen beitragen. Zunächst jedoch müssen die Eigenschaften der Leberzelle erst einmal in datenbasierte mathematische Formeln und Modelle gegossen werden - eine experimentell und analytisch hoch komplexe Aufgabe, deren sich das HepatoSys-Kompetenznetzwerk mit inzwischen vier Forschungsverbünden und zwei Forschungsplattformen angenommen hat.
Im Stuttgarter Verbund entwirft und testet Insilico Biotechnology als Dienstleister im Bereich Systembiologie den Stoffwechsel der Leberzelle am Computer und verantwortet dabei insbesondere die Bestimmung kinetischer Parameter mit Hilfe von Höchstleistungsrechnern.
Als Industriepartner hat der Prozessentwickler zudem die Federführung in einem Teilprojekt zum Thema „Stoffwechseldynamik" übernommen.
Vernetzt arbeiten
Zusammen mit der Berliner Humboldt-Universität, dem Stuttgarter Dr. Margarete Fischer-Bosch-Institut für Klinische Pharmakologie und der Universität Stuttgart erarbeitet man ein umfassendes dynamisches Stoffwechselmodell, das die Abbauvorgänge in der Leber beschreibt und dabei laufend die Ergebnisse der anderen Teilprojekte integriert.
Um aussagefähige Simulationsmodelle zu generieren, reicht es nicht aus, die genauen molekularen Charakteristika und intrazellulären Konzentrationen einer Leberzelle zu kennen. Vielmehr ist es erforderlich, die Wechselwirkungen und Dynamiken zwischen den einzelnen Komponenten dieses Zellsystems zu erfassen, da nur so das biochemische Reaktionsnetzwerk kinetisch, unter Berücksichtigung möglichst aller Reaktionspartner, beschrieben werden kann.
Da dem Enzymsystem bei der Biotransformation körpereigener und fremder Stoffe in ausscheidungsfähige Formen eine herausragende Rolle zukommt, ist seine Erforschung von entscheidender Bedeutung für das Wissen über Quantität und Qualität von Medikamentenwirkungen. Um die Abhängigkeit der Zellreaktionen von der Enzymkonzentration zu untersuchen, stellen die Forscher deren Parameter im Modell nach.
In einem ersten Schritt sollen die physischen Eigenschaften verschiedener Personengruppen nachgestellt werden. Im nächsten Schritt will man die Eingangssignale, vor allem die Medikamentendosen, abwandeln.
Ziel ist die Erstellung eines quantitativen enzymkinetischen Modells zur Beschreibung des Verhaltens der Leberzelle unter dynamischen Bedingungen - eine Art Schaltplan, der zeigt, wie die Komponenten miteinander „verknüpft" sind. Bisher wurden bereits mehr als 400 Metabolite, also Abbauprodukte und Abbauzwi schenprodukte biochemischer Stoffwechselvorgänge, in das Modell integriert.
Dabei entstehen riesige Datensätze, die sich nur noch mittels „Supercomputing" bewältigen und interpretieren lassen. Das Unternehmen greift hierfür auf seine eigene Modellierungsund Simulationssoftware „Insilico Discovery" und die Rechenleistung des schnellsten Vektorrechners in Europa, der im Höchstleistungsrechenzentrum der Universität Stuttgart steht, zurück.
Bioregio Stern
In der baden-württembergischen Region Stuttgart, Tübingen, Esslingen, Reutlingen und Neckar-Alb ist die Bioregio Stern Management GmbH gemeinsames Kompetenznetzwerk, Anlauf- und Beratungsstelle für Existenzgründer, Unternehmer und Forscher im Bereich Biotechnologie. Das Netzwerk fördert die Zusammenarbeit unterschiedlichster Disziplinen wie Medizin, Bioverfahrenstechnik, Sensorik, Ernährungswissenschaft, biochemische Analytik und Bioinformatik.
Bedeutende Schwerpunkte bilden die Regenerationsbiologie und die Medizintechnik. Man vertritt die Interessen der Existenzgründer, Unternehmer und Forscher gegenüber Politik, Medien und Verbänden, bündelt Wirtschaftsförderung und Marketing, berät bei Förderanträgen und Unternehmensfinanzierungen.
Unterstützt wird man dabei von den Regionen Stuttgart und Neckar-Alb sowie den Städten Stuttgart, Tübingen, Esslingen und Reutlingen. Geschäftsführer ist der Molekular- und Zellbiologe und Investmentanalyst Dr. Klaus Eichenberg.
Infokasten Systembiologie
Die Systembiologie ist ein relativ junger Zweig der Biowissenschaften. Sie verfolgt das Ziel, mittels mathematischer Modellierung, computerbasierter und ingenieurwissenschaftlicher Analyse zu einem theoretischen Verständnis komplexer biologischer Prozesse und Systeme zu gelangen.
Die große Fülle von Daten über einzelne Zellbestandteile und deren Funktionen kann mit Hilfe von Biologie, Informatik und Systemwissenschaften in einen sinnvollen Gesamtzusammenhang gebracht und in prädiktiven Modellen im Computer nachgebildet werden.
Der Forschungsansatz wird mittel- bis langfristig eine Vielzahl neuer und innovativer Anwendungen in der Medizin - z. B. bei der Identifizierung relevanter Zielstrukturen für die patientenbezogene Entwicklung von Medikamenten und Therapien -, in der Biotechnologie - z. B. als Ersatz von Tiermodellen für die Wirkstofftestung - und in anderen Bereichen ermöglichen.
Kontakt
Dr. Klaus Eichenberg
Bioregio Stern Management GmbH, Stuttgart
Tel.: 0711/8703540
www.bioregio-stern.de
www.insilico-biotechnology.com
Meist gelesen

Verluste, die keiner sieht
In CCUS-Projekten der chemischen Industrie wird die präzise CO₂-Messung zur Schlüsseltechnologie - Coriolis-Systeme spielen dabei eine zentrale Rolle.

Radikaler Schnitt für gesundes Wachstum – CHT stellt sich neu auf
Die CHT Group gehört zu den Hidden Champions der deutschen Spezialchemie.

Continuous Manufacturing ganzheitlich bewerten
Die Investitionsentscheidung für eine kontinuierliche Produktion bedarf einer belastbaren Wirtschaftlichkeitsrechnung entlang des gesamten Prozesses.

Single-Site Excellence
Interview mit Frank Wegener und Jörg Blumhoff, ESIM Chemicals, über die Wettbewerbssituation und ihre künftige Strategie im weltweiten CDMO-Markt.

Chemiekonjunktur – China auf der Überholspur
Im Jahr 2024 stieg der Anteil Chinas an den globalen Chemieinvestitionen auf rund 45 %. Doch die goldenen Jahre des chinesischen Wirtschaftswunders sind vorbei.




